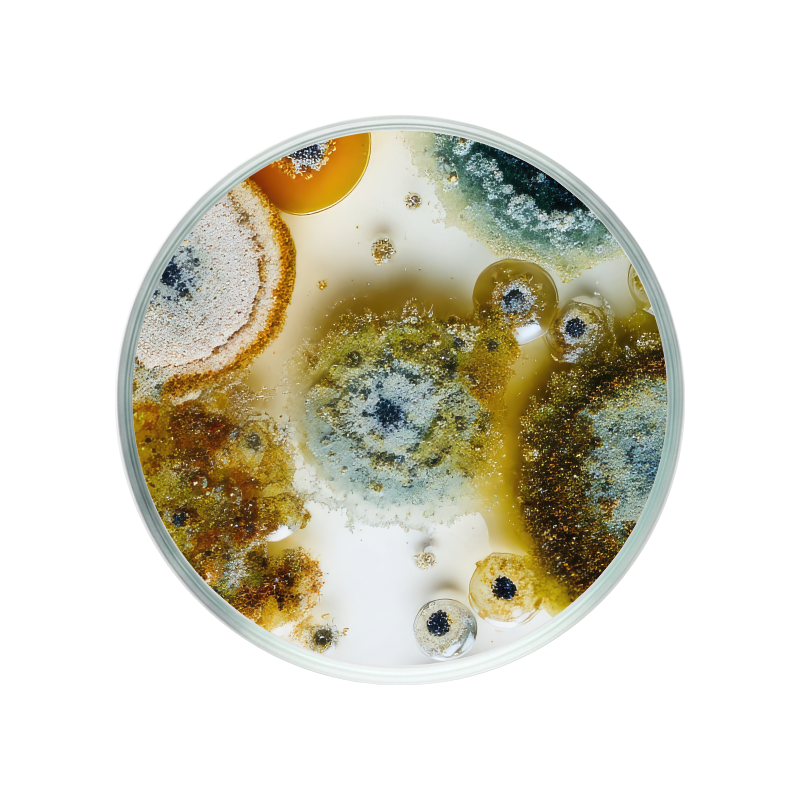

Heb je vragen?
Aanvullend advies? Geen probleem! Vraag het ons team van experten. We horen graag van je.
Je winkelwagen
Ontvang een gratis pillendoosje bij €120 — Gebruik de code FREEPILLBOX.
Je winkelwagen is leeg
Terugkeren naar winkelGratis levering
Alleen €45,00 resterend om de gratis levering te ontgrendelen
Besteloverzicht
Gratis pillendoosje vanaf €120 — code: FREEPILLBOX.
Pectinase is een enzym dat van nature voorkomt in verschillende soorten fruit en groenten. Het speelt een rol in het afbreken van pectine, een complexe suiker die te vinden is in de celwanden van planten. Pectine draagt bij aan de structuur van plantencellen en beïnvloedt de textuur van diverse vruchten.
Pectinase kan op verschillende manieren worden geproduceerd. Het kan worden afgeleid van schimmels, bacteriën of zelfs uit plantaardige bronnen. Meestal wordt de enzymatische activiteit versterkt door fermentatieprocessen. Hierbij worden micro-organismen in gecontroleerde omgevingen ingezet om pectinase te ontwikkelen.
De specifieke functie van dit enzym in de menselijke spijsvertering wordt volop onderzocht. Wat specifiek onderzocht wordt is de bijdrag aan het afbreken van pectine in voedsel, wat mogelijk effect heeft op de opname van voedingsstoffen.
Pectinase richt zich specifiek op de afbraak van pectine. Terwijl andere enzymen zoals amylase en protease zich bezighouden met respectievelijk de afbraak van zetmeel en eiwitten.
Ja, pectinase is ook verkrijgbaar in de vorm van een supplement. Zo zit het in de Insentials Gut Day.

Aanvullend advies? Geen probleem! Vraag het ons team van experten. We horen graag van je.